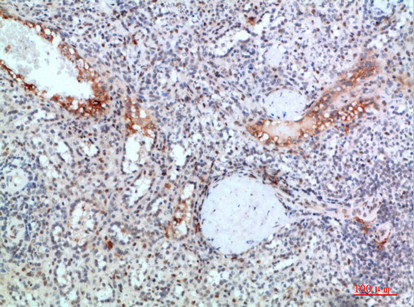

TICAM1 Antibody
-
中文名稱:TICAM1兔多克隆抗體
-
貨號(hào):CSB-PA544544
-
規(guī)格:¥1090
-
圖片:
-
Western Blot analysis of HEPG2 cells using TRIF Polyclonal Antibody diluted at 1:1000. Secondary antibody was diluted at 1:20000
-
Immunohistochemical analysis of paraffin-embedded human-lung-cancer, antibody was diluted at 1:200
-
Immunohistochemical analysis of paraffin-embedded human-lung-cancer, antibody was diluted at 1:200
-
Immunohistochemical analysis of paraffin-embedded human-spleen, antibody was diluted at 1:200
-
Immunohistochemical analysis of paraffin-embedded human-spleen, antibody was diluted at 1:200
-
-
其他:
產(chǎn)品詳情
-
Uniprot No.:
-
基因名:
-
別名:TICAM1; PRVTIRB; TRIF; TIR domain-containing adapter molecule 1; TICAM-1; Proline-rich, vinculin and TIR domain-containing protein B; Putative NF-kappa-B-activating protein 502H; Toll-interleukin-1 receptor domain-containing adapter protein inducing interferon beta; MyD88-3; TIR domain-containing adapter protein inducing IFN-beta
-
宿主:Rabbit
-
反應(yīng)種屬:Human
-
免疫原:Synthesized peptide derived from TRIF at AA range: 663-712
-
免疫原種屬:Homo sapiens (Human)
-
標(biāo)記方式:Non-conjugated
-
純化方式:The antibody was affinity-purified from rabbit antiserum by affinity-chromatography using epitope-specific immunogen.
-
濃度:It differs from different batches. Please contact us to confirm it.
-
保存緩沖液:Liquid in PBS containing 50% glycerol, 0.5% BSA and 0.02% sodium azide.
-
產(chǎn)品提供形式:Liquid
-
應(yīng)用范圍:WB,ELISA
-
推薦稀釋比:
Application Recommended Dilution WB 1:500-2000 ELISA 1:10000-20000 -
Protocols:
-
儲(chǔ)存條件:Upon receipt, store at -20°C or -80°C. Avoid repeated freeze.
-
貨期:Basically, we can dispatch the products out in 1-3 working days after receiving your orders. Delivery time maybe differs from different purchasing way or location, please kindly consult your local distributors for specific delivery time.
-
用途:For Research Use Only. Not for use in diagnostic or therapeutic procedures.
相關(guān)產(chǎn)品
靶點(diǎn)詳情
-
功能:Involved in innate immunity against invading pathogens. Adapter used by TLR3, TLR4 (through TICAM2) and TLR5 to mediate NF-kappa-B and interferon-regulatory factor (IRF) activation, and to induce apoptosis. Ligand binding to these receptors results in TRIF recruitment through its TIR domain. Distinct protein-interaction motifs allow recruitment of the effector proteins TBK1, TRAF6 and RIPK1, which in turn, lead to the activation of transcription factors IRF3 and IRF7, NF-kappa-B and FADD respectively. Phosphorylation by TBK1 on the pLxIS motif leads to recruitment and subsequent activation of the transcription factor IRF3 to induce expression of type I interferon and exert a potent immunity against invading pathogens. Component of a multi-helicase-TICAM1 complex that acts as a cytoplasmic sensor of viral double-stranded RNA (dsRNA) and plays a role in the activation of a cascade of antiviral responses including the induction of proinflammatory cytokines.
-
基因功能參考文獻(xiàn):
- These data indicate a novel role of the TLR3-TICAM-1 pathway in controlling miR-21 levels in extracellular vesicles. PMID: 29679565
- Findings suggest that Toll/IL-1R domain-containing adapter-inducing IFN-beta may be involved in the epileptogenesis of temporal lobe epilepsy, which would make it a potential therapeutic target for the treatment of epilepsy. PMID: 28867282
- Data suggest that endosomal localization of TICAM2 is essential for TLR4-mediated type I interferon-inducing signaling from endosomes; TICAM2 acts as scaffold protein and activates TICAM1; N-terminal myristoylation allows TICAM2 to anchor to endosomal membrane. (TICAM2 = toll like receptor adaptor molecule-2; TICAM1 = toll like receptor adaptor molecule-1; TLR4 = toll-like receptor 4) [REVIEW] PMID: 28630139
- Data suggest that pro-death signals through TIR-domain-containing adapter-inducing interferon-beta (TRIF) are regulated by autophagy and propose that pro-apoptotic signalling through TRIF/RIPK1/caspase-8 occurs in fibrillary platforms. PMID: 28453927
- TRIF gene may contribute to susceptibility of T2DM. PMID: 28479387
- The NF-kappaB activated by dsRNA appears not to be the canonical p65/p50 heterodimers. PMID: 28052863
- IL-12p70 production requires uptake of Streptococcus pneumoniae as well as the presence of the adaptor molecule TRIF. PMID: 26956584
- TIRF high-content imaging system simultaneously showed the expression pattern of EGFRs and EC50 value for CPT-induced apoptosis and necrosis in MCF-7, SK-BR-3 and JIMT-1 cancer cell line PMID: 26886741
- involved in signaling that moderates the expression of heme oxygenase1 and il-8 after keratinocytes exposure to dinitrochlorobenzene PMID: 25377948
- signaling through TRIF is important for the inflammatory response of AngII-induced abdominal aortic aneurysm formation PMID: 26100679
- Data show that toll-like receptor 3/TRIF protein signalling regulates cytokines IL-32 and IFN-beta secretion by activation of receptor-interacting protein-1 (RIP-1) and tumour necrosis factor receptor-associated factor 6 (TRAF6) in cornea epithelial cells. PMID: 25754842
- In mice with nonfunctional TRIF (Trif(mut) mice), Ang II-induced hypertension and cardiac hypertrophy were abrogated, and proinflammatory gene expression in heart and kidneys was unchanged or decreased. These results indicate that Ang II induces activation of a proinflammatory innate immune response, causing hypertension and cardiac hypertrophy, which require functional adaptor protein TRIF-mediated pathways. PMID: 26195481
- TRIF promotes angiotensin II-induced cross-talk between fibroblasts and macrophages in atrial fibrosis. PMID: 26056004
- amino-terminal 21 amino acid sequence is crucial for TRAF3 association, protein stability and activation of the IFN pathway PMID: 24577058
- required, in combination with MyD88, for TLR4-mediated proinflammatory dendritic cell differentiation PMID: 23941760
- findings show that TRIF activates IRF3 through a phosphorylation-dependent mechanism; results reveal that phosphorylation of innate adaptor proteins is an essential and conserved mechanism that selectively recruits IRF3 to activate the type I IFN pathway PMID: 25636800
- PTX3 binds MD-2 and promotes TRIF-dependent immune protection in aspergillosis. PMID: 25049357
- MUC1 has a role in regulating epithelial inflammation and apoptosis by PolyI:C through inhibition of TRIF recruitment to Toll-like receptor 3 PMID: 24693944
- Enterovirus 68 3C protease cleaves TRIF to attenuate antiviral responses mediated by TLR3. PMID: 24672048
- TRIF-N-terminal helical domain shares structural similarity with IFIT5. PMID: 24311583
- IL-32-PAR2 axis is an innate immunity sensor providing alternative signaling for LPS-TRIF axis. PMID: 24129891
- required for HLA class I antigen presentation during Hantavirus infection PMID: 23824566
- Data indicate that TIR domain containing adaptor inducing IFN-beta protein (TRIF), as well as TLR3 activation, enhances Kaposi's sarcoma-associated herpesvirus (KSHV) replication and transcription activator (RTA) protein expression. PMID: 23723066
- TRIM38 may act as a novel negative regulator for TLR3-mediated type I interferon signaling by targeting TRIF for degradation PMID: 23056470
- ADAM15 acts as a negative regulator of TRIF-mediated NF-kappaB and IFN-beta reporter gene activity via TLR3 and TLR4 signaling. PMID: 23365087
- anti-beta(2)GPI/beta(2)GPI complex induced TF and TNF-alpha expression involving both TLR4/MyD88 and TLR4/TRIF signaling pathways and TLR4 and its adaptors might be molecular targets for therapy of antiphospholipid syndrome PMID: 22964479
- TICAM1 down-regulation was found to be dependent on TLR3 but not RIG1, MDA5, or PKR and appeared to be regulated post-translationally PMID: 22205631
- Data show that The TRIF-selective signaling response resulted in the production of substantially less of the proinflammatory mediators. PMID: 22337809
- the D299G polymorphism compromises recruitment of MyD88 and TRIF to TLR4 without affecting TLR4 expression, TLR4-MD2 interaction, or LPS binding, suggesting that it interferes with TLR4 dimerization PMID: 22474023
- TRIF may play an important role in the pathogenesis of antiphospholipid syndrome. PMID: 22152804
- regulation of the TLR3/TRIF-mediated pathway required the combined action of SHP-1 and SHP-2, which could be accomplished by CD300f but not CD300a PMID: 22043923
- The TLR2/4 ligand biglycan enhances antigen-specific T cell priming via MyD88 and Toll-like receptor adapter molecule TRIF pathways, triggering autoimmune perimyocarditis in transgenic mice. PMID: 22095710
- Hepatitis A virus inhibits TLR3 signaling by reducing abundance of the adaptor protein TRIF. PMID: 21931545
- Susceptibility to herpes simplex encephalitis is caused by TRIF nonsense (autosomal recessive) TRIF deficiency or a missense mutation (autosomal dominant). TRIf is needed for TLR3-dependent interferon synthesis. PMID: 22105173
- The host TICAM-1 transgene pathway is essential for antiviral responses that suppress poliovirus infection, which is exacerbated in TICAM-1-deficient poliovirus receptor-bearing mice. PMID: 21998457
- show that hBD3 reduces NF-kappaB signaling in cells transfected with MyD88 or TRIF PMID: 21809339
- These studies establish that MyD88 but not Trif signaling plays a critical role in mediating cardiac dysfunction, systemic inflammation, and mortality during polymicrobial sepsis PMID: 21792053
- PLIC-1 is a novel inhibitor of the TLR3-Trif antiviral pathway by reducing the abundance of Trif PMID: 21695056
- TRIF cleavage mediated by human enterovirus 71 3C protease may be a mechanism to impair type I interferon production in response to Toll-like receptor 3 (TLR3) activation. PMID: 21697485
- KSHV employs a novel mechanism to block the innate immunity by degrading TRIF protein. PMID: 21212282
- TRIF protein induces soluble tumor necrosis factor receptor 1 (TNFR1) shedding via signaling from human airway epithelial cells (NCI-H292) with subsequent activation of two downstream pathways. PMID: 21148036
- Silencing TRIF expression reduces TLR5-induced NFkappaB, JNK1/2, and ERK1/2 activation in human colonic epithelial cells. PMID: 20855887
- Data show that mutant TICAM-1 failed to recruit the IRF-3 kinase TBK1, resulting in lack of IRF-3 phosphorylation. PMID: 20418377
- TRIF modulates TLR5-dependent responses by inducing proteolytic degradation of TLR5 PMID: 20452988
- Consistent with results for total tumor necrosis factor (TNF)-alpha messenger RNA (mRNA) levels, lipopolysaccharide-stimulated Trif transgenic and wild-type bone marrow-derived dendritic cells generate comparable amounts of TNF-alpha transcripts. PMID: 20375303
- SARM-mediated inhibition may not be exclusively directed at TRIF or MyD88, but that SARM may also directly inhibit MAPK phosphorylation PMID: 20306472
- TRIS was associated with TRIF upon TLR3 activation by poly(I-C). These findings reveal an unexpected mechanism of TLR3-mediated signaling. PMID: 20200155
- The binding of TRAF2 and TRAF6 to TICAM-1 cooperatively activates the IFN-inducing pathway through ubiquitination of TICAM-1. PMID: 20047764
- TRIF is identified and characterized as a novel adaptor protein containing the Toll/IL-1 receptor domain, with a specific role in TLR3 signaling. PMID: 12471095
- identified an alternative adaptor, designated Toll-interleukin 1 receptor domain (TIR)-containing adaptor molecule (TICAM)-1, that can physically bind the TIR domain of TLR3 PMID: 12539043
顯示更多
收起更多
-
相關(guān)疾病:Herpes simplex encephalitis 4 (HSE4)
-
亞細(xì)胞定位:Cytoplasmic vesicle, autophagosome. Cytoplasm, cytosol. Mitochondrion.
-
組織特異性:Ubiquitously expressed but with higher levels in liver.
-
數(shù)據(jù)庫鏈接:
Most popular with customers
-
-
YWHAB Recombinant Monoclonal Antibody
Applications: ELISA, WB, IHC, IF, FC
Species Reactivity: Human, Mouse, Rat
-
Phospho-YAP1 (S127) Recombinant Monoclonal Antibody
Applications: ELISA, WB, IHC
Species Reactivity: Human
-
-
-
-
-